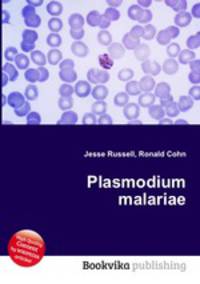
Plasmodium malariae

Поиск книг, учебников, пособий в онлайн-магазинах
Plasmodium malariae
Автор: Jesse Russell,Ronald Cohn, 101 стр., издатель: "Книга по Требованию", ISBN: 978-5-5081-1613-2High Quality Content by WIKIPEDIA articles! Plasmodium malariae is a parasitic protozoa that causes malaria in humans. It is closely related to Plasmodium falciparum and Plasmodium vivax which are responsible for most malarial infection. While found worldwide, it is a so-called "benign malaria" and is not nearly as dangerous as that produced by P. falciparum or P. vivax. P. malariae causes fevers that recur at approximately three-day intervals (a quartan fever), longer than the two-day (tertian) intervals of the other malarial parasites, hence its alternate names quartan fever and quartan malaria. Данное издание представляет собой компиляцию сведений, находящихся в свободном доступе в среде Интернет в целом, и в информационном сетевом ресурсе "Википедия" в частности. Собранная по частотным запросам указанной тематики, данная компиляция построена по принципу подбора близких информационных ссылок, не имеет самостоятельного сюжета, не содержит никаких аналитических материалов, выводов,...
Рейтинг книги: 


 4 из 5, 5 голос(-ов).
4 из 5, 5 голос(-ов).



 4 из 5, 5 голос(-ов).
4 из 5, 5 голос(-ов).




